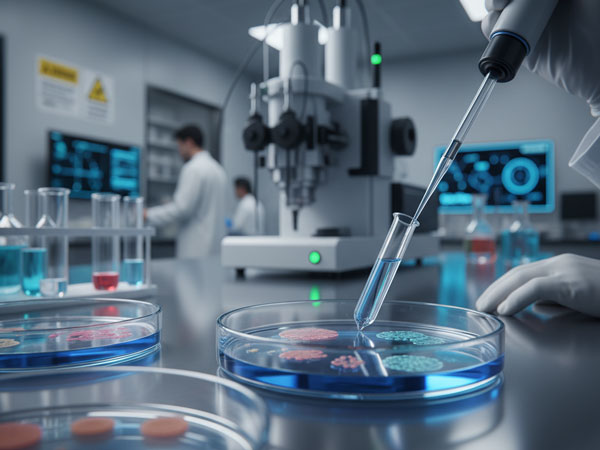
Testy_04_600x450_1

Testované v nezávislom laboratóriu

KVALITA A TESTOVANIE - VEDECKY OVERENÉ A LABORATÓRNE POTVRDENÉ
Naše produkty patria medzi najkvalitnejšie laboratórne testované výživové doplnky s obsahom vitálnych húb. Prechádzajú dôsledným testovaním v nezávislých, akreditovaných laboratóriách, ktoré pracujú podľa noriem ISO 17025 a GMP (Good Manufacturing Practice).
Cieľom je zaručiť, že každý produkt je bezpečný, čistý a vedecky overený.

OVERENÝ PÔVOD A IDENTITA SUROVÍN
Každá použitá huba pochádza z certifikovaných zdrojov. Suroviny sú testované modernými metódami ako HPLC, FTIR a DNA barcoding, ktoré potvrdzujú ich pravosť a biologickú identitu. Tým zaručujeme, že každý produkt obsahuje pravé extrakty z vitálnych húb a rastlín, nie lacné náhrady alebo mycélium bez účinku.


OBSAH BIOAKTÍVNYCH LÁTOK
Naše laboratórne testované doplnky majú presne definovaný obsah β-glukánov, triterpenoidov, ergosterolu a ďalších aktívnych zlúčenín, ktoré sú zodpovedné za ich účinky na imunitu, energiu a regeneráciu.
Každý produkt prechádza kvantitatívnou analýzou podľa medzinárodných metodík (AOAC, EN ISO) - aby sme mohli garantovať skutočný obsah účinných látok uvedený na obale.


TESTY ČISTOTY A BEZPEČNOSTI
Všetky doplnky sú dôkladne testované na ťažké kovy (olovo, kadmium, ortuť, arzén), pesticídy, mikrobiologické kontaminácie (napr. E. coli, Salmonella) aj zvyšky rozpúšťadiel.
Dôležité!!! Huby prirodzene absorbujú látky z prostredia, preto je nezávislé laboratórne testovanie kľúčové pre bezpečnosť a kvalitu.
Naše produkty spĺňajú prísne európske normy pre bezpečné výživové doplnky.


CERTIFIKÁT KVALITY (COA)
Každá šarža je sprevádzaná Certifikátom analýzy (Certificate of Analysis) vydaným nezávislým laboratóriom.
Tento dokument potvrdzuje:
- pravosť a pôvod suroviny,
- obsah bioaktívnych látok,
- výsledky testov čistoty a mikrobiológie,
- zhodu so štandardmi kvality.
Zákazník má tak istotu, že produkt, ktorý užíva, je vedecky overený, transparentne testovaný a predstavuje najvyššiu úroveň kvality v oblasti medicinálnych húb.

DÔVERA POSTAVENÁ NA VEDE
Nezávislé testovanie nie je pre nás formalita - je to náš záväzok k zodpovednosti, transparentnosti a vašej dôvere. Naše laboratórne testované doplnky prinášajú kombináciu prírodnej sily vitálnych húb a vedecky podloženej kvality.
Každý produkt, ktorý držíte v rukách, prešiel overením, nie len marketingom.


TRANSPARENTNOSŤ
Zverejňujeme výsledky testov - laboratórne testované doplnky s certifikátom kvality dostupným na požiadanie.

